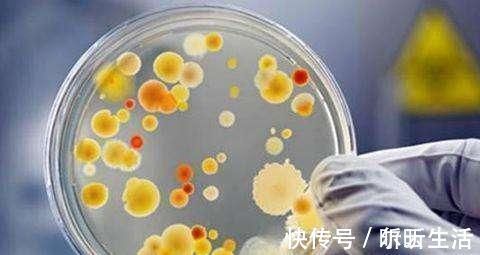
食用|猪肉放在冰箱,超过这个时间,就快点扔掉吧,不要再心疼食用了

食用|猪肉放在冰箱,超过这个时间,就快点扔掉吧,不要再心疼食用了
猪肉是人们餐桌上重要的动物性食品之一。猪肉含丰富的蛋白质、脂肪、碳水化合物、钙、磷、铁等成分,具有补虚强身、滋阴润燥、丰肌泽肤的作用。另外,猪肉纤维较细软,结缔组织较少,肌肉组织中肌间脂肪较多,烹调加工后非常鲜美。但是如果我们一不小心买多了,该怎样正确储存?要知道猪肉也是有一定保存期限的,猪肉放在冰箱,超过这个时间,就快点扔掉吧,不要再心疼食用了!

文章插图
新鲜猪肉怎么保存?
(1)有冰箱:将猪肉切片,放置冰箱冻硬,再用塑料薄膜侧层包裹起来,重新放回冷冻室,一个月不变质!
(2)没冰箱:将猪肉切块,装进干净的盆里,把煮沸的酱油放凉后倒进盆中,淹没猪肉,盖上盖子,不需要放进冰箱,2-3个月保持新鲜。
(3)腌制法:将没沾过水的猪肉用米酒浸渍并搓搽后,高高挂于通风处,1-2个月久放不坏,且能保持肉的鲜味。

文章插图
一、冷却:主要用于短时间存放的肉品,通常使肉中心温度降低到0℃~1℃左右。具体要求是,肉在放入冰箱前,先将冷冻室降到零下4℃左右,肉入冷冻室后,保持-1℃~0℃之间。猪肉冷却时间为24小时,可保存5~7天。经过冷却的肉,表面形成一层干膜,从而阻止细菌生长,并减缓水分蒸发,延长保存时间。但是,如果冷冻室还有其他的东西,就会有影响了。

文章插图
二、冷冻:就是直接放入-18℃的冷冻室中。不过,我一般都要进行分装,就是我每餐吃多少,我就把肉切成多大的几块,用保鲜袋装好。吃时就只拿出一块,提前半个多小时拿出来放入凉水中解冻(不可用热水)。这样的肉还是很鲜嫩。基本一周左右口感还是不会差的。保存期限为4-5个月,最多不能超过半年,冷冻温度最好在-15℃至-16℃。
文章插图
误区:冰箱=保鲜柜?
很多微生物繁殖的适宜温度范围为4℃—60℃,而大部分冰箱冷藏温度并没有达到4℃以下,即使达标,也只能延缓细菌的生长繁殖,并不能杀灭微生物。此外,长时间存放往往会发生冰晶析出、裂缝、粘连等现象。一些速冻食品更不能长期冷藏,反复冷冻导致维生素缓慢分解损失,长期食用可能引起胃肠疾病。
【 食用|猪肉放在冰箱,超过这个时间,就快点扔掉吧,不要再心疼食用了】如果您喜欢本文章,欢迎动动手指点“赞”并收藏转发,您的支持是对小编莫大的鼓励,谢谢您!
特别声明:本站内容均来自网友提供或互联网,仅供参考,请勿用于商业和其他非法用途。如果侵犯了您的权益请与我们联系,我们将在24小时内删除。
